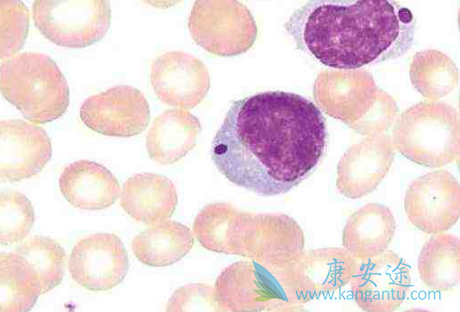
��³����

依鲁替尼(IBRUTINIB)除对恶性 B 细胞的生存和凋亡具有直接作用外,越来越多的证据还显示,该药物能够调节肿瘤的微环境,从而克服免疫逃避机制。这激起了人们将该药物应用于恶性淋巴肿瘤以外疾病的兴趣。目前该药已被 FDA 和 EMA 批准用于 CLL 的任何线治疗,还适用于 MCL 的二线治疗,以及此前至少接受过一种基于抗-CD20 的治疗方案的边缘区淋巴瘤(MZL)患者。
依鲁替尼治疗边缘区淋巴瘤:在之前接受过至少一种含抗-CD20 治疗的 R/R MZL 患者中开展的一项开放性 II 期研究中评价了伊布替尼的疗效(Noy et al. 2017)。入选的 63 例患者的中位年龄为 66 岁(30-92)。患者之前结果接受过的治疗数中位值为 2。经过中位值为 19.4 个月的随访之后,ORR 达到 48%,无进展生存期中位值为 14.2 个月。
根据此项研究,依鲁替尼(IBRUTINIB)被批准用于此前至少接受过一种含抗-CD20 治疗的 R/R MZL 患者。目前正在进行的一项 Ⅲ 期试验(SELENE 研究)中评价了 BR 或 R-CHOP 免疫化疗的基础上加用依鲁替尼或安慰剂。
详情请访问 肿瘤 https://www.kangantu.com/
















请简单描述您的疾病情况,我们会有专业的医学博士免费为您解答问题(24小时内进行电话回访)